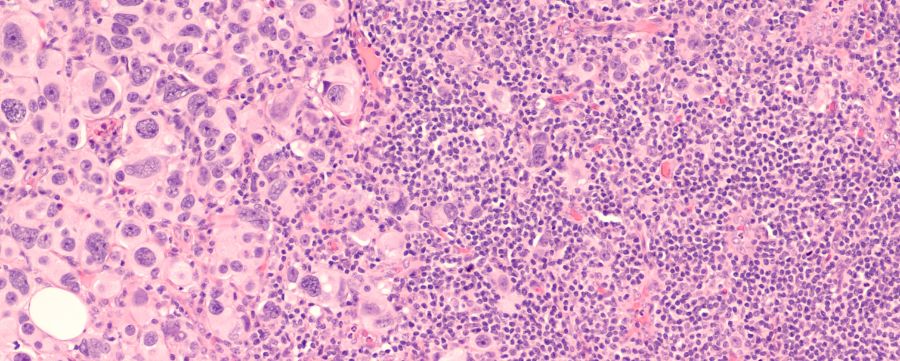
Ganglio Centinela

Ganglio Centinela
¿Qué es Ganglio Centinela?
Un ganglio centinela es aquel al que se ha diseminado un tumor maligno. Detectarlo es crucial para que los médicos puedan saber en qué estadio se encuentra un tipo de cáncer y cuántos ganglios de estas características hay para extirparlos en un procedimiento quirúrgico. De esta manera, se podrá controlar la propagación de la enfermedad.
Cuando las células cancerosas están presentes en un ganglio centinela, esto quiere decir que el cáncer puede haberse propagado, ya, a otras partes del cuerpo, lo que podría estar indicando que se ha producido una metástasis. Por lo tanto, un diagnóstico temprano y la extirpación de los ganglios centinela es fundamental para conseguir un buen pronóstico.
En ocasiones, además de la extirpación de un ganglio centinela hay que acompañar esto de un tratamiento adicional, como puede ser la quimioterapia o radioterapia. Esto ocurre cuando el ganglio contiene células cancerosas. En el caso de que esto no sea así, es menos probable que se haya diseminado a otras partes del organismo.
En definitiva, el ganglio centinela es un concepto importante en el ámbito de la oncología que ayuda a evaluar en qué estadio se encuentra un cáncer para tratarlo de forma adecuada y poder mejorar el pronóstico del paciente.
